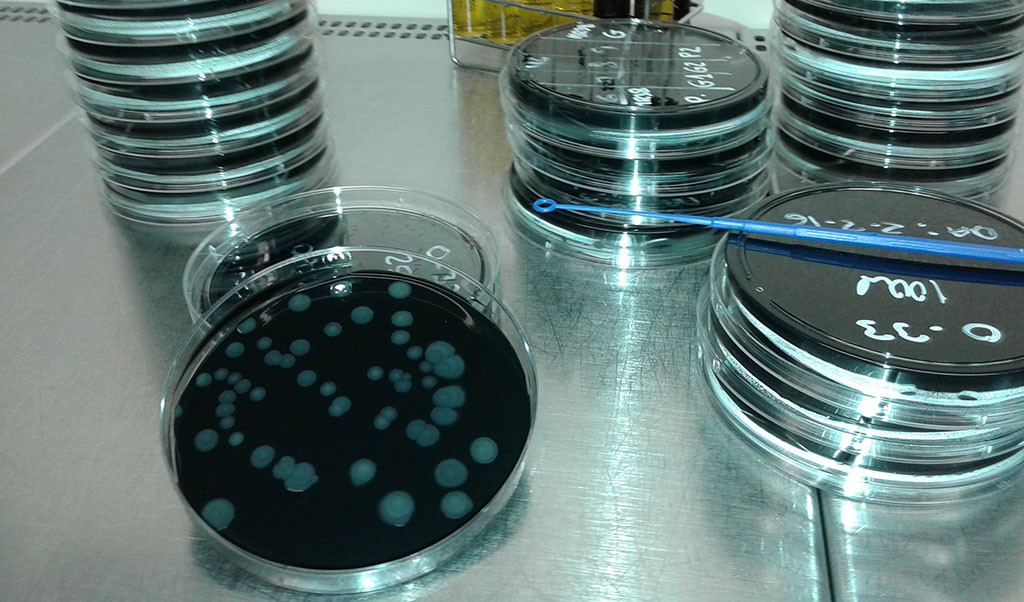

C/Padilla nº 73. 28006 MADRID. Telfs: 656 383 407 - 609 876 616 E-mail: info@mygeco.es
Convertimos la Sostenibilidad y el Control Ambiental en una Ventaja Competitiva para su empresa. Acompañamos en la integración de criterios ESG, el Cálculo y Comunicación de tu Impacto Ambiental y la Gestión Normativa de sus Aguas, con soluciones innovadoras y seguras que refuercen la confianza de sus clientes y el valor de su marca.
Nuestro objetivo es apoyar a su organización en el cumplimiento Normativo, así como una comunicación transparente de resultados
Somos especialistas en el Diseño e Implantación de los Planes exigidos por la Normativa en vigor:

Análisis integral de situación actual y definición de indicadores clave. Integración completa de criterios ESG en la estrategia de negocio, alineada con las exigencias del mercado y la normativa europea para clientes e inversores
Cálculo de la huella de carbono para cumplimiento de normativa 214/2025
Cálculo de impacto ambiental de producto: análisis de ciclo de vida
Comunicación de impacto ambiental y huella de carbono en etiquetado, posicionamiento de marca y como ventaja competitiva
Comunicación de datos a clientes, cumplimiento legal.
Diseño especializado de planes de control sanitario en aguas de consumo humano, control de calidad en aguas purificadas, planes de control sanitario y prevención de legionelosis según normativa actualizada
Implementación completa según R.D. 487/22 y R.D. 614/24. Diseño de PPCL y planes analíticos especializados.
Limpieza y desinfección profesional de instalaciones. Planes de control integral en redes de aguas purificadas industriales.
Optimización completa de planes analíticos y estudio de las mejores ofertas técnicas para subcontratación de análisis especializados
Soluciones integrales desde el mantenimiento en cámaras hasta análisis completo. Implantación de GMP's y normas de correcta fabricación.
© 2025 Mygeco Consulting. Todos los derechos reservados - Aviso Legal - Política de Cookies - Desarrollo: hc_design